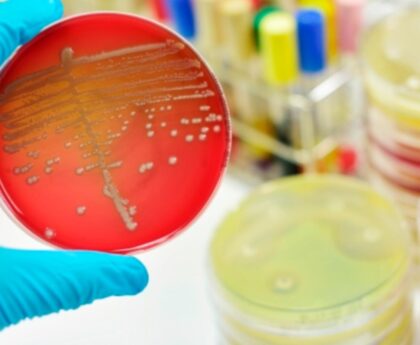

În fiecare săptămână, în zilele de joi și duminică, Loteria Română organizează extrageri loto la toate categoriile de joc, inclusiv Loto 6/49, Joker, 5/40, Noroc, Super Noroc și Noroc Plus.
Rezultatele loto duminică, 8 ianuarie 2023: numerele câștigătoare la extragerile de azi
Rezultate Loto la Joker, 8 ianuarie 2023: 6 7 10 3 1 + 4
Rezultate Loto la Noroc Plus, 8 ianuarie 2023: 8 4 2 7 5 4
Rezultate Loto la Super Noroc, 8 ianuarie 2023: 5 8 1 6 3 2
Rezultate Loto la Noroc, 8 ianuarie 2023: 3 4 7 1 3 5 7
Rezultate la Loto 5 din 40, 8 ianuarie 2023: 30 8 3 11 28 14
Rezultate la Loto 6 din 49, 8 ianuarie 2023: 42 37 2 24 16 6